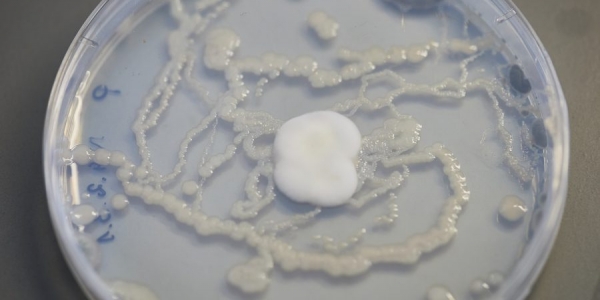

Centrum Nauk Biologiczno-Chemicznych UW, kierownik projektu – prof. Johannes Ehrenfried Zschech – poszukuje kandydatów do pracy w ramach projektu badawczego M-ERA.NET 2 Call 2019 finansowanym przez Narodowe Centrum Nauki. Tytuł projektu: „Synteza i charakterystyka nowych materiałów hybrydowych 2 D do zastosowań jako superkondensatory”, akronim HYSUCAP Stanowisko: Termin wysyłania zgłoszeń: 16 maja 2021 r. Więcej ofert […]